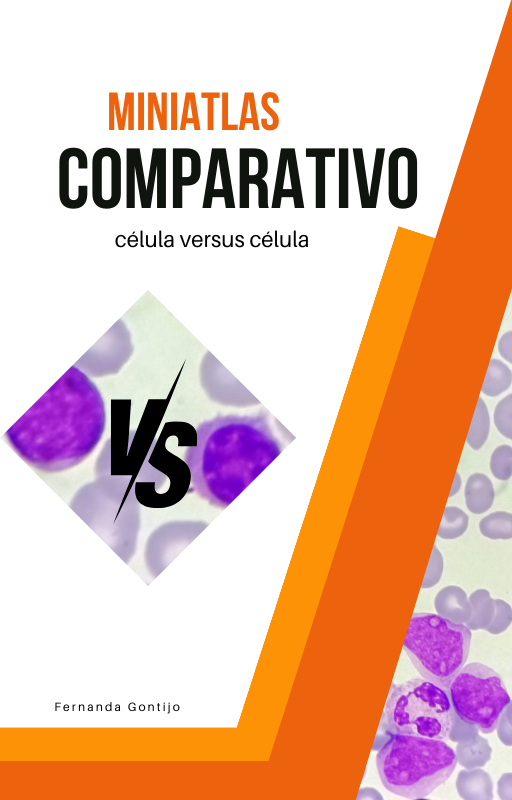
Miniatlas Comparativo - Célula versus Célula

📖 "Miniatlas Comparativo: Célula versus Celular"
O eBook essencial para quem deseja explorar o fascinante mundo microscópico das células de forma envolvente e educativa!
Com 45 páginas repletas de ilustrações detalhadas, este eBook oferece uma comparação morfológica entre duas células hematológicas, proporcionando uma compreensão visual única.
📚 O que você vai encontrar:
✔️ Comparação morfológica entre células hematológicas, com detalhes que ajudam a distinguir suas características essenciais.
✔️ Ilustrações vívidas e detalhadas, tornando o aprendizado mais visual e fácil de compreender.
✔️ Descrição detalhada de cada célula, guiando você em uma jornada educativa pelo universo celular.
💡 Por que este eBook é indispensável para você?
✔️ Leitura envolvente e visualmente cativante, ideal para entusiastas da hematologia e profissionais da saúde que desejam aprofundar seu conhecimento.
✔️ Compreensão aprofundada da complexidade celular, com foco na diversidade das células hematológicas.
✔️ Ferramenta essencial para estudantes e profissionais, ajudando a desenvolver uma base sólida no estudo das células.
🚀 Mergulhe no fascinante mundo das células e amplie seu conhecimento com este miniatlas comparativo exclusivo!
Miniatlas Comparativo - Célula versus Célula
Com suas 45 páginas ricamente ilustradas, este ebook colorido oferece uma comparação morfológica envolvente entre duas células hematológicas.
Descubra as características únicas de cada célula enquanto uma descrição detalhada e ilustrações vívidas proporcionam uma jornada educativa e visualmente cativante no universo das células.
Prático para consultas do lado do microscópio.